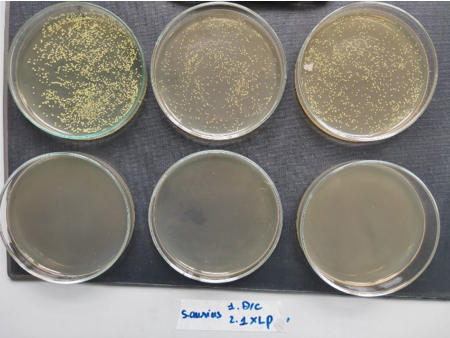
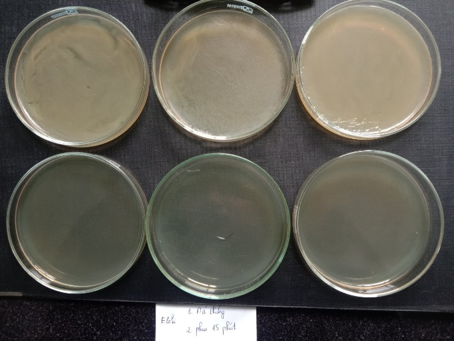

Nhóm các nhà nghiên cứu trẻ và sinh viên tại Phòng Thí nghiệm Trọng điểm Công nghệ Mico-Nano (VMINA LAB) thuộc Trường Đại học Công nghệ, ĐHQGHN (VNU-UET), vừa trình làng bộ đôi sản phẩm: Máy sát khuẩn tay và máy khử khuẩn phòng kín tự động.
Nghiên cứu sinh Hồ Anh Tâm cho biết, điểm đặc biệt của cả 2 thiết bị này đã được thí nghiệm kiểm tra khả năng sát khuẩn và tối ưu hóa vận hành, công năng.
Các thí nghiệm kiểm tra khả năng diệt khuẩn của thiết bị được thực hiện bởi TS. Hà Thị Quyến (VNU-UET), chuyên ngành Vi sinh vật học phối hợp thực hiện với các nghiên cứu viên tại Trung tâm giống và bảo tồn nguồn gen vi sinh vật thuộc Viện Công nghệ Sinh học, Viện Hàn lâm Khoa học Việt Nam (VAST). Dung dịch khử khuẩn cũng được nhóm nghiên cứu tự pha chế theo tiêu chuẩn của WHO.
Kết quả thử nghiệm thiết bị với vi khuẩn. 3 đĩa ở hàng trên tương ứng là không phun dung dịch, và 3 đĩa hàng dưới là các đĩa có phun dung dịch nên vi khuẩn không phát triển được. Hình trên thực hiện với máy rửa tay, với mức phun 0.7ml. Hình dưới thực hiện với máy khử khuẩn buồng kín, thời gian phun 15 phút
Máy sát khuẩn tay tự động:
Hiện nay tại các cửa cơ quan, doanh nghiệp hầu hết đều trang bị các lọ dung dịch rửa tay sát khuẩn. Tuy nhiên, việc tất cả mọi người đều phải tiếp xúc lên lọ dung dịch lại tạo ra một nguồn lây nhiễm tiềm năng. Hơn nữa, việc không có một định lượng chính xác dung dịch cần để diệt khuẩn cho mỗi lần rửa tay khiến cho người dùng hoặc không phun đủ lượng dung dịch cần thiết, hoặc phun quá nhiều gây lãng phí dung dịch. Ngoài ra nhiều đơn vị phải bố trí người túc trực thường xuyên để nhắc nhở việc rửa tay gây lãng phí nhân lực và tăng nguy cơ lây nhiễm.
Do vậy, nhiều cơ sở đã nghiên cứu chế tạo và đưa vào sử dụng các máy sát khuẩn tay tự động bơm dung dịch. Điểm đặc biệt của máy sát khuẩn tay tự động do Vmina Lab chế tạo là tích hợp nhiều tính năng thân thiện với người sử dụng như khi có người đi tới, máy tự động phát ra lời nhắc mọi người rửa tay. Khi rửa chỉ cần xòe 2 bàn tay ra đưa vào buồng sát khuẩn máy sẽ sử dụng 4 vòi phun tự động phun dung dịch sát khuẩn lên bề mặt da tay và tự động ngắt khi đã phun đủ thời lượng tối ưu theo kết quả thí nghiệm khả năng sát khuẩn. Điều này đảm bảo vừa tiết kiệm dung dịch mà vẫn đảm bảo chắc chắn khả năng sát khuẩn (là tính năng chính của máy). Thiết bị được tích hợp trên 1 chân đế chắc chắn, di chuyển được và rất phù hợp đặt tại sảnh các công sở, cơ quan, khách sạn,… nơi có nhiều người qua lại cần sát khuẩn tay thường xuyên, tránh tình trạng mọi người dùng tay ấn trực tiếp vào các chai sát khuẩn để lấy dung dịch/gel sát khuẩn ra tay. Thiết bị cũng được thiết kế buồng đựng dung dịch tương đối lớn để đảm bảo máy có thể hoạt động liên tục trong nhiều ngày mới phải tiếp thêm dung dịch sát khuẩn. Máy cũng phát cảnh báo khi dung dịch cạn để người dùng cho thêm dung dịch.
* Máy sát khuẩn buồng kín
Nhiều nghiên cứu đã chỉ ra rằng các không gian kín tụ tập đông người là điều kiện lý tưởng để virus có thể lây lan thông qua các giọt bắn rất nhỏ mà mắt người không thể nhìn thấy được (https://www.youtube.com/watch?v=H2azcn7MqOU). Chính vì vậy việc sát khuẩn thường xuyên đối với buồng kín có ý nghĩa rất lớn trong việc ngăn chặn sự lây lan của virus vi khuẩn. Tuy nhiên việc phun khử khuẩn bằng dung dịch cloramin B lại có nhiều điểm hạn chế như gây mùi khó chịu, hay tạo ra độ ẩm lớn, tính oxy hoá và ăn mòn cao làm hỏng hóc các thiết bị trong phòng. Việc sát khuẩn thủ công bằng các dung dịch tẩy rửa khác lại gây ra các tác động không tốt lên sức khỏe người thực hiện.
Máy sát khuẩn buồng kín được chế tạo để hạn chế các tác động nói trên. Dung dịch cồn dưới tác dụng của sóng siêu âm sẽ tạo thành khí dung với các hạt có kích thước chỉ cỡ micro-mét, dễ dàng phân tán trong không gian và diệt khuẩn hiệu quả. Cồn có tác dụng khử khuẩn mà không gây hại lên các thiết bị máy móc trong phòng. Máy có tích hợp bộ đếm thời gian cho phép người dùng có thể phun theo thời gian đặt trước phù hợp với kích thước của phòng mà không cần phải trực tiếp tham gia vào quá trình khử khuẩn, do đó không gây hại tới sức khỏe.
Cả 2 thiết bị nói trên đã được nghiên cứu tối ưu thông số và quy trình vận hành. VMINA Lab sẵn sàng chuyển giao công nghệ chế tạo thiết bị cho các đơn vị quan tâm theo email hoanhtam@vnu.edu.vn.
Tham khảo về nguy cơ lây nhiễm virus trong phòng kín: https://www.youtube.com/watch?v=H2azcn7MqOU
Thông tin báo chí:
– Báo Nhân dân: Ra mắt hai thiết bị sát khuẩn tự động
– Báo Pháp luật: ĐHQGHN vừa ra mắt bộ đôi sát khuẩn tự động
Theo Ngọc Diệp – Ngọc Tùng (VNU Media)